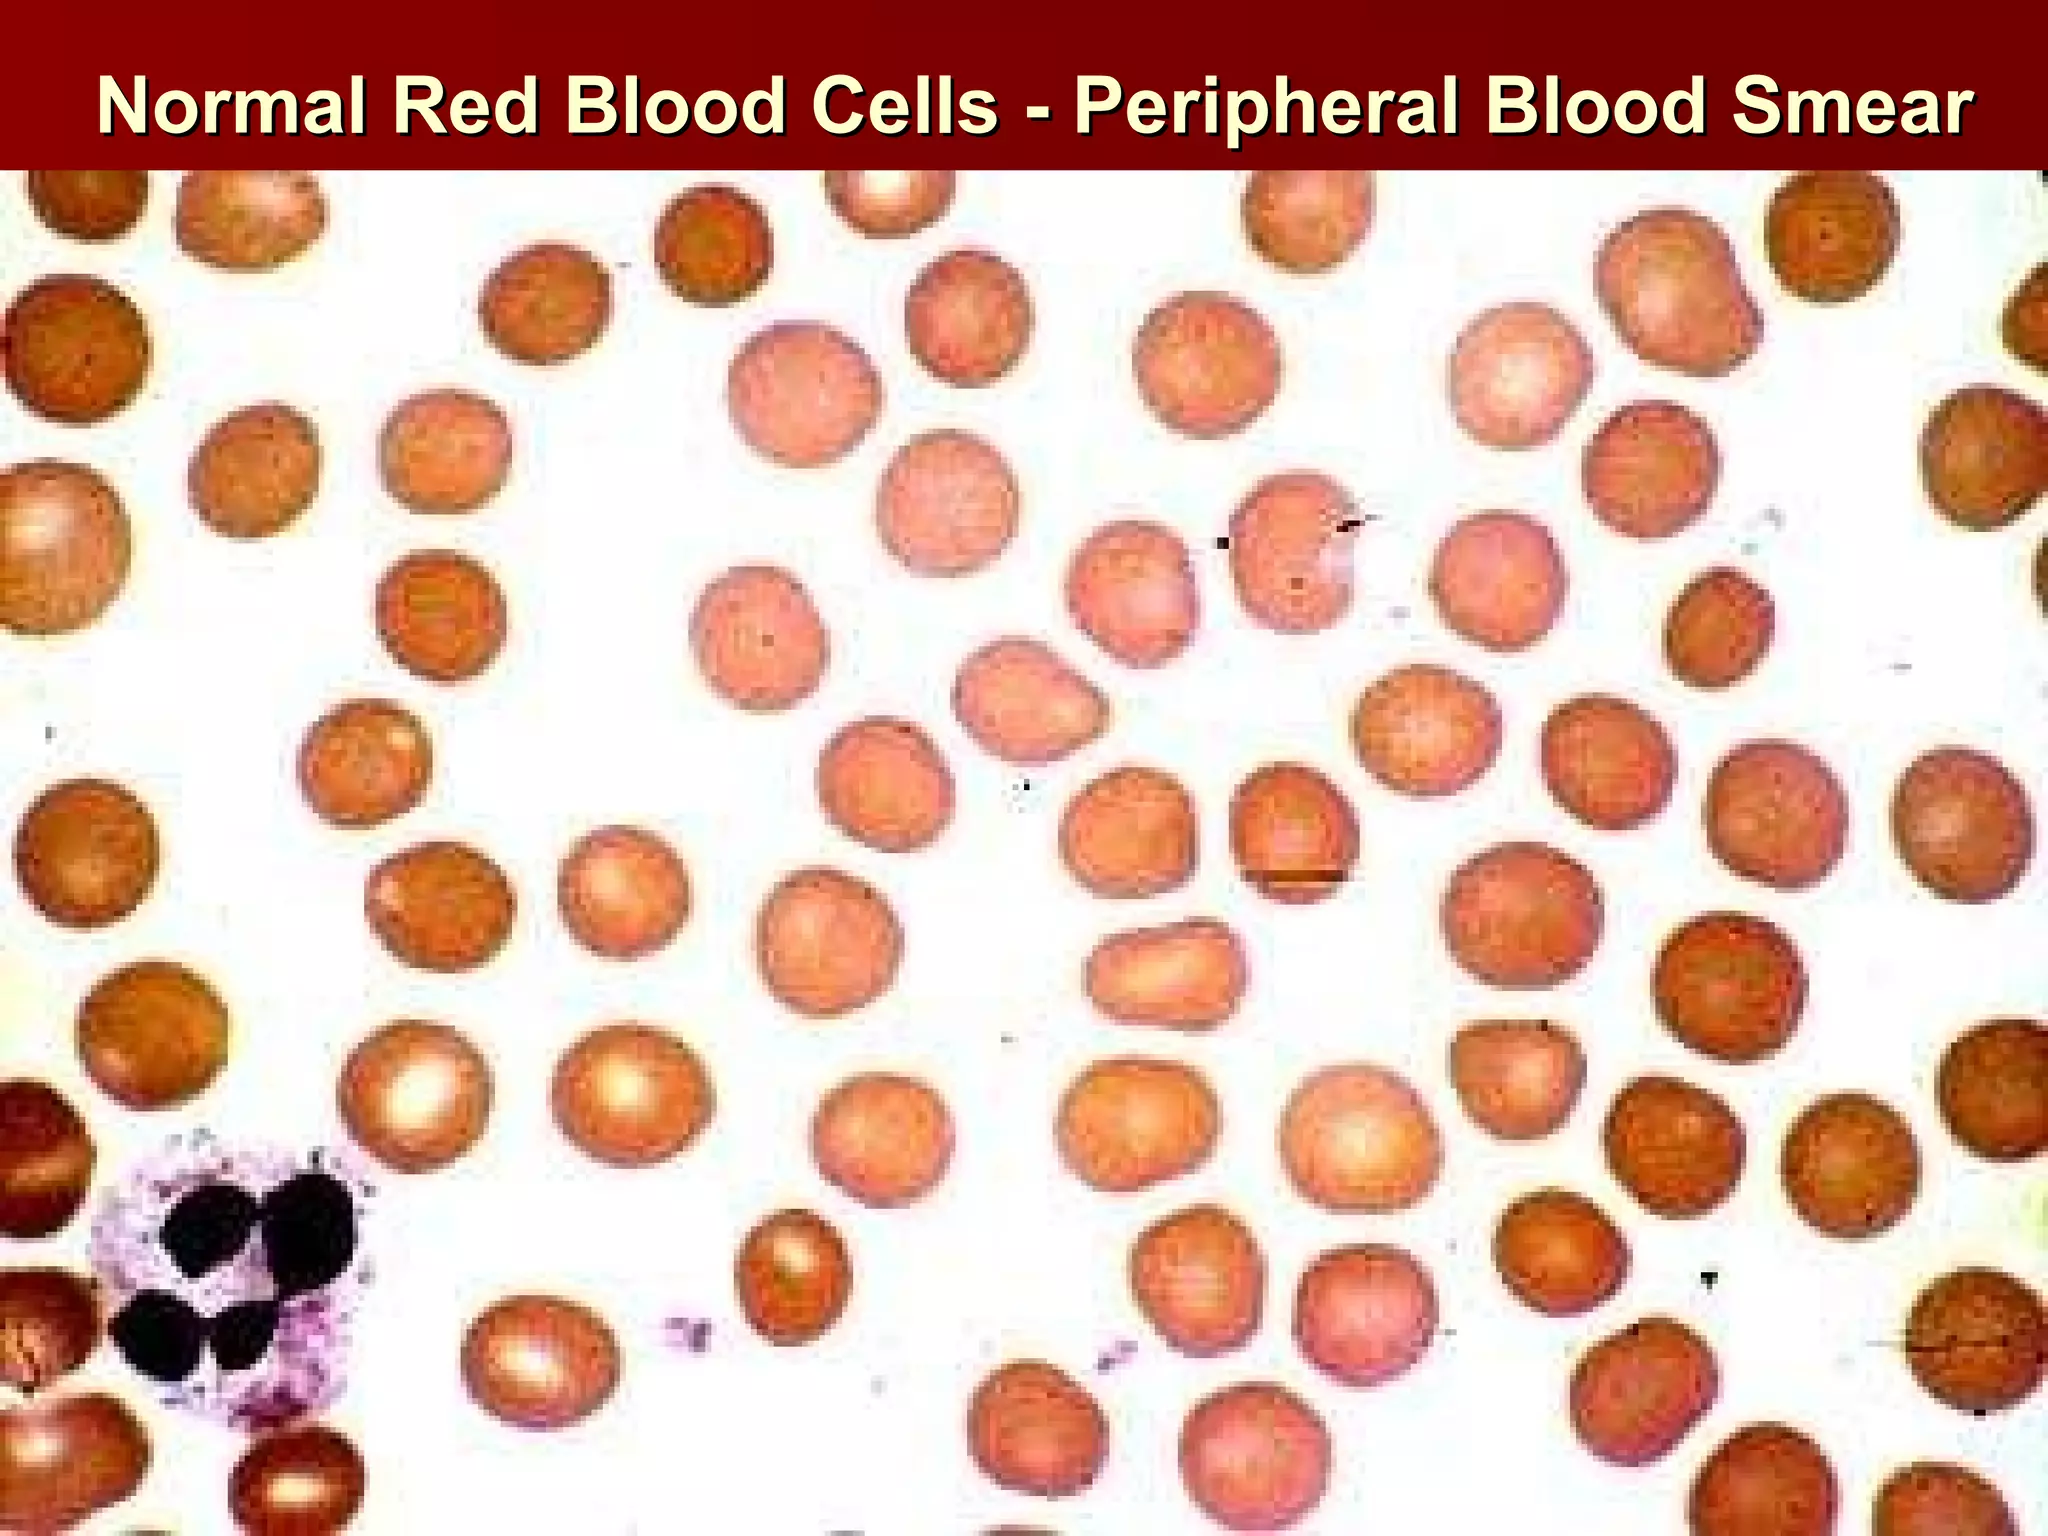
Normal Red Blood Cells - Peripheral Blood Smear
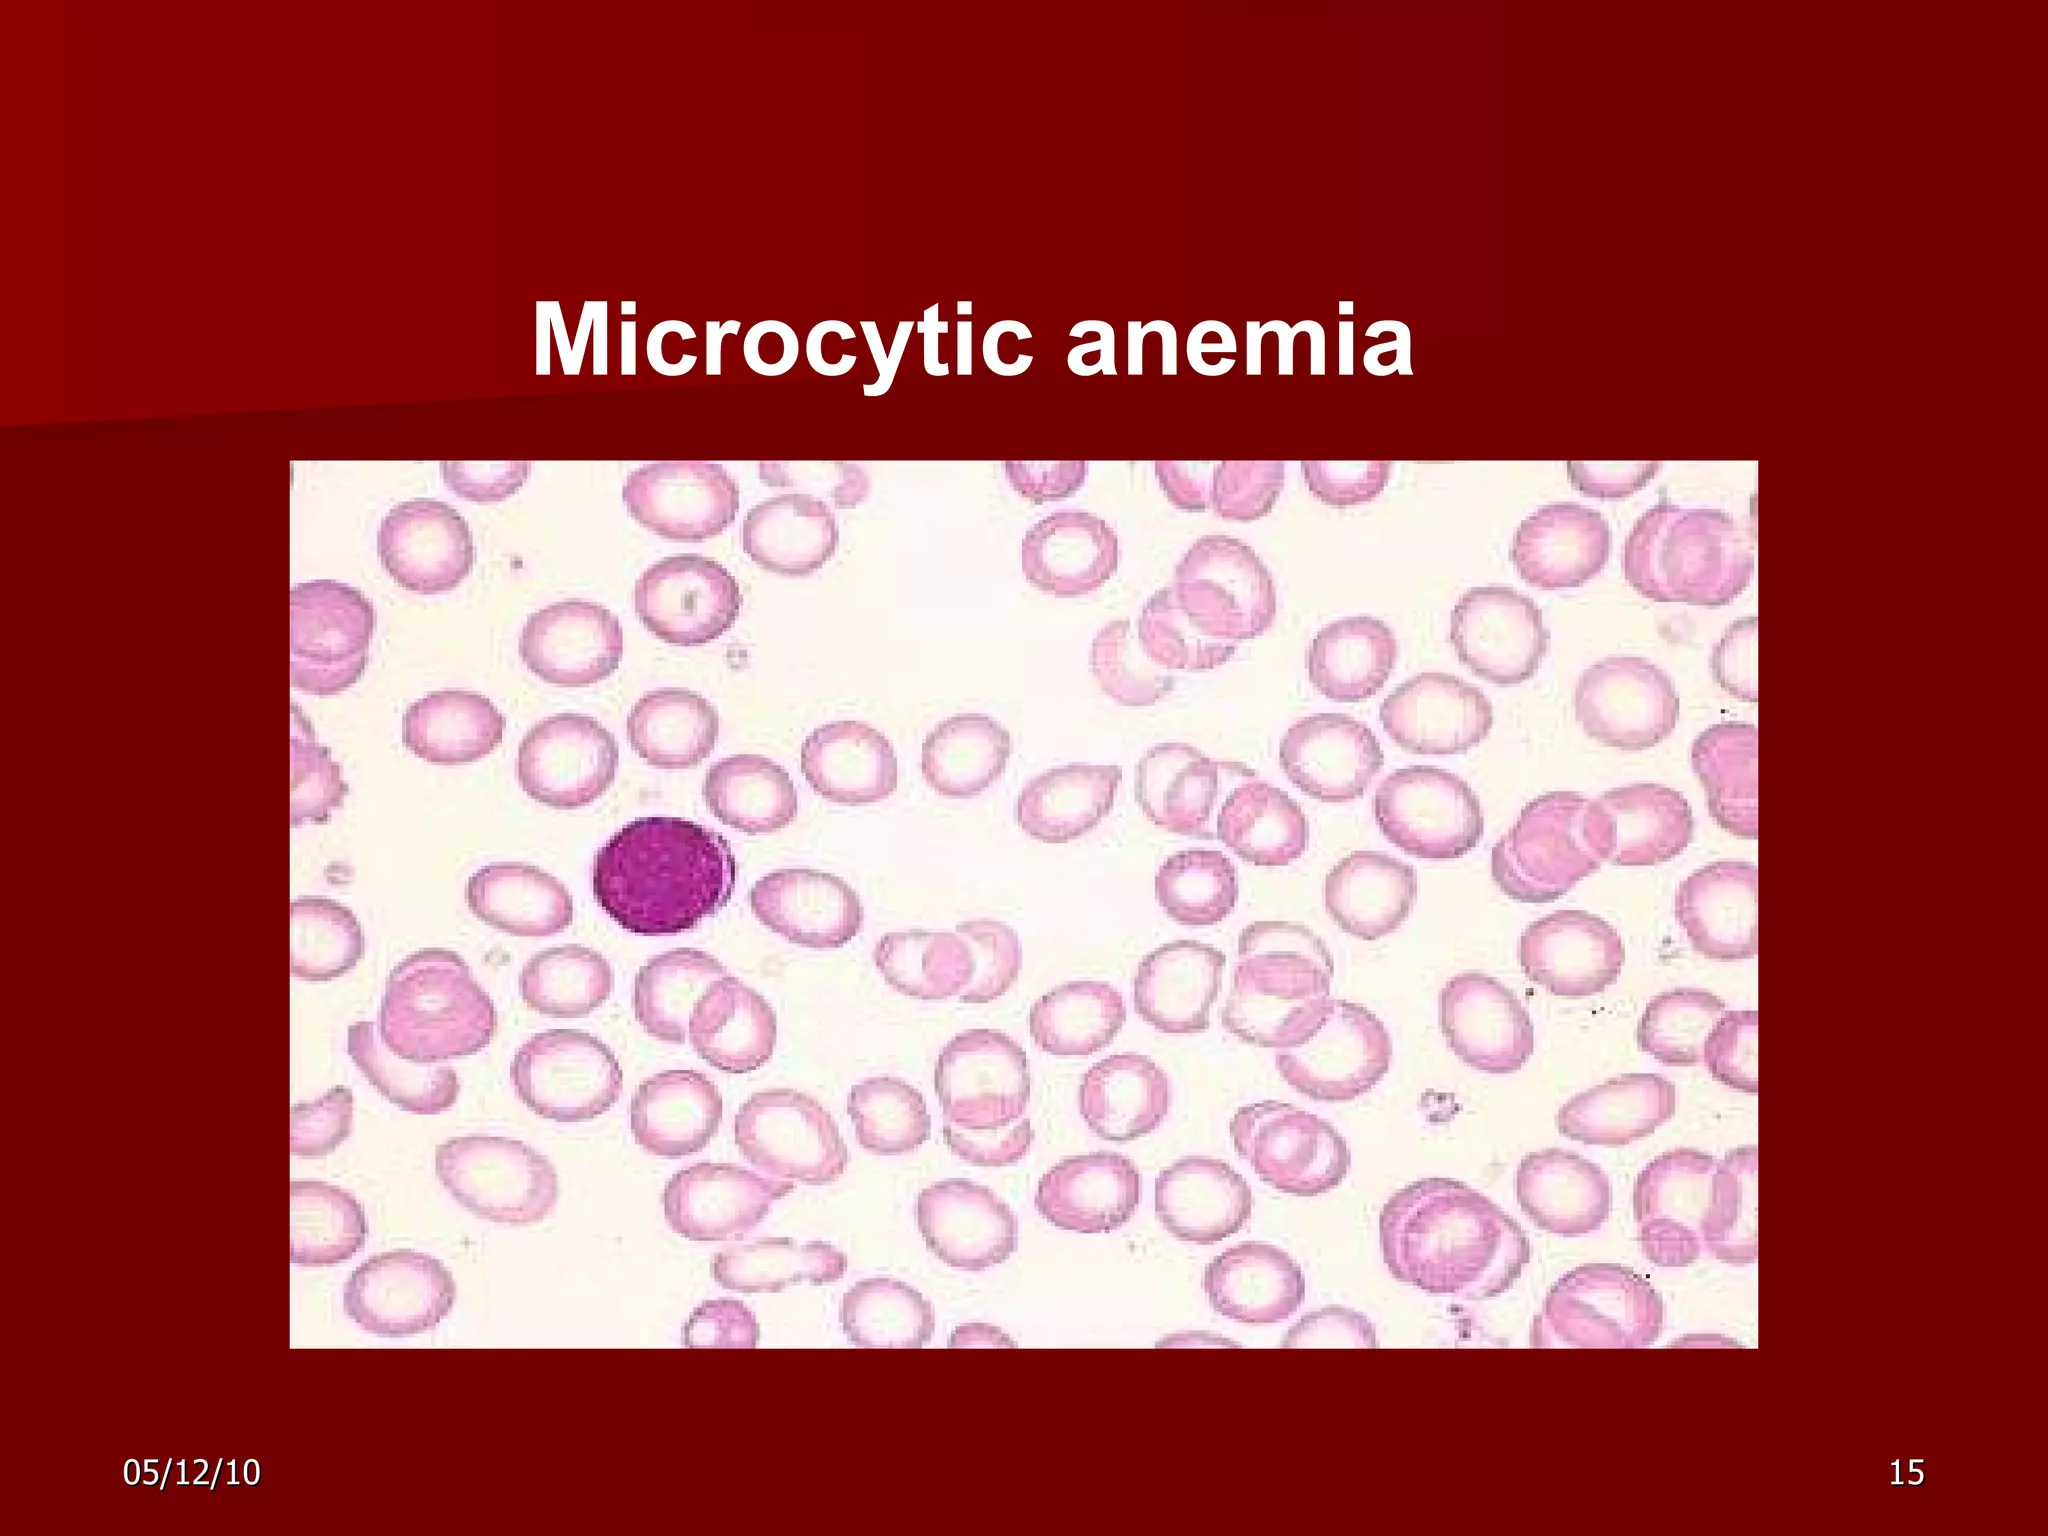
Microcytic anemia
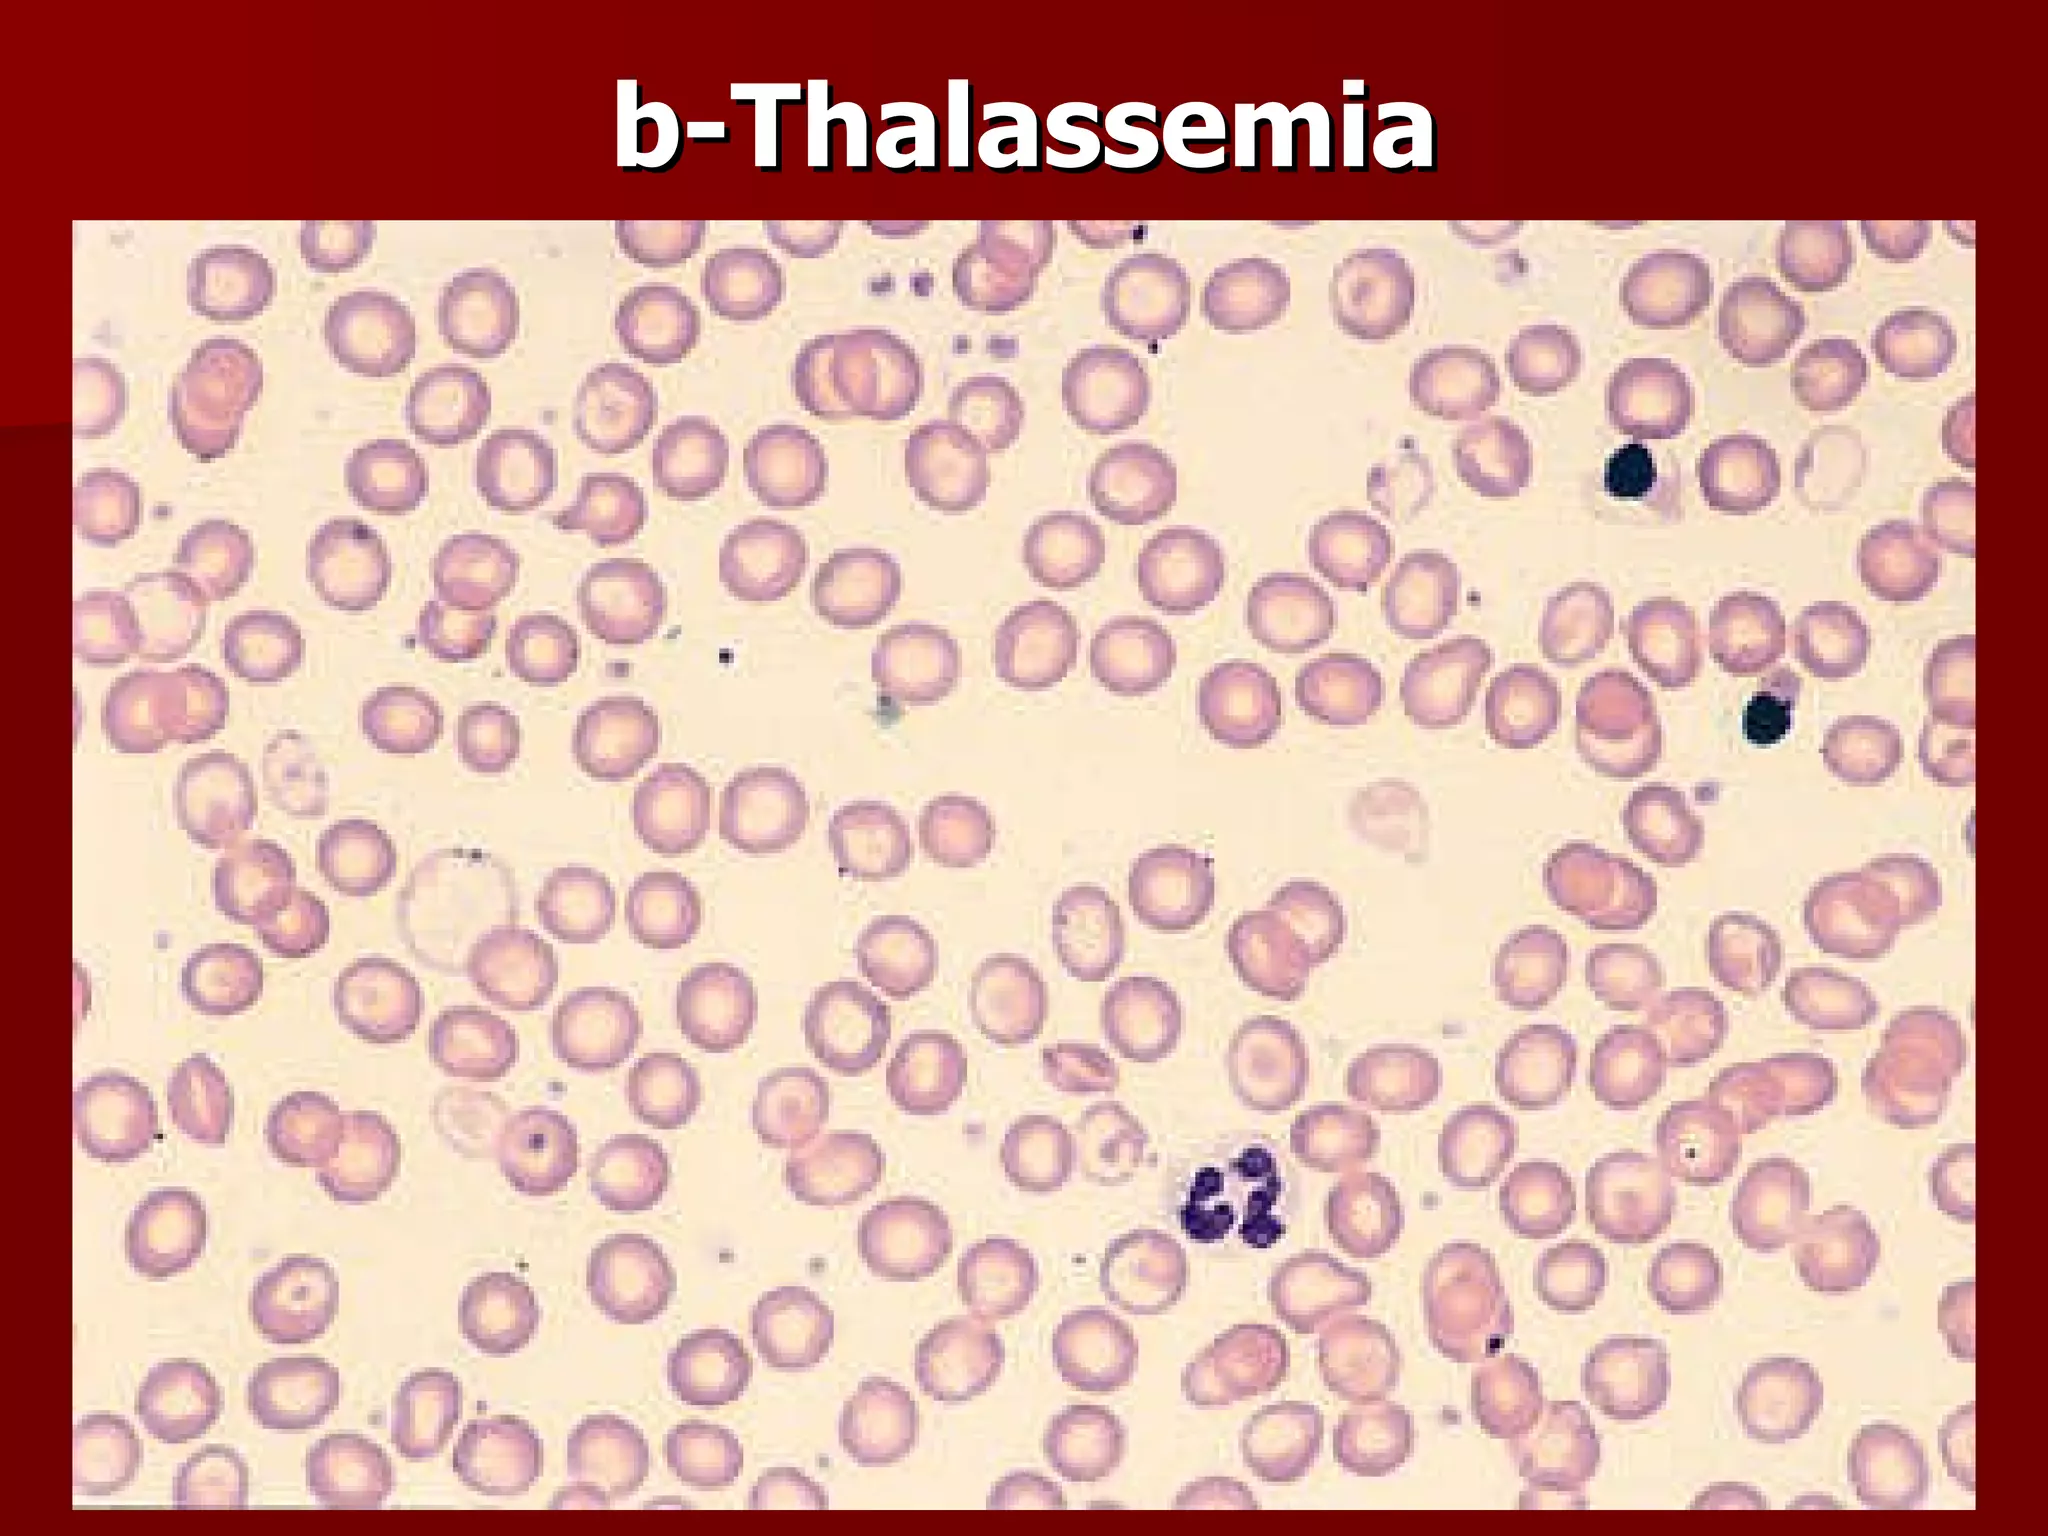
b-Thalassemia
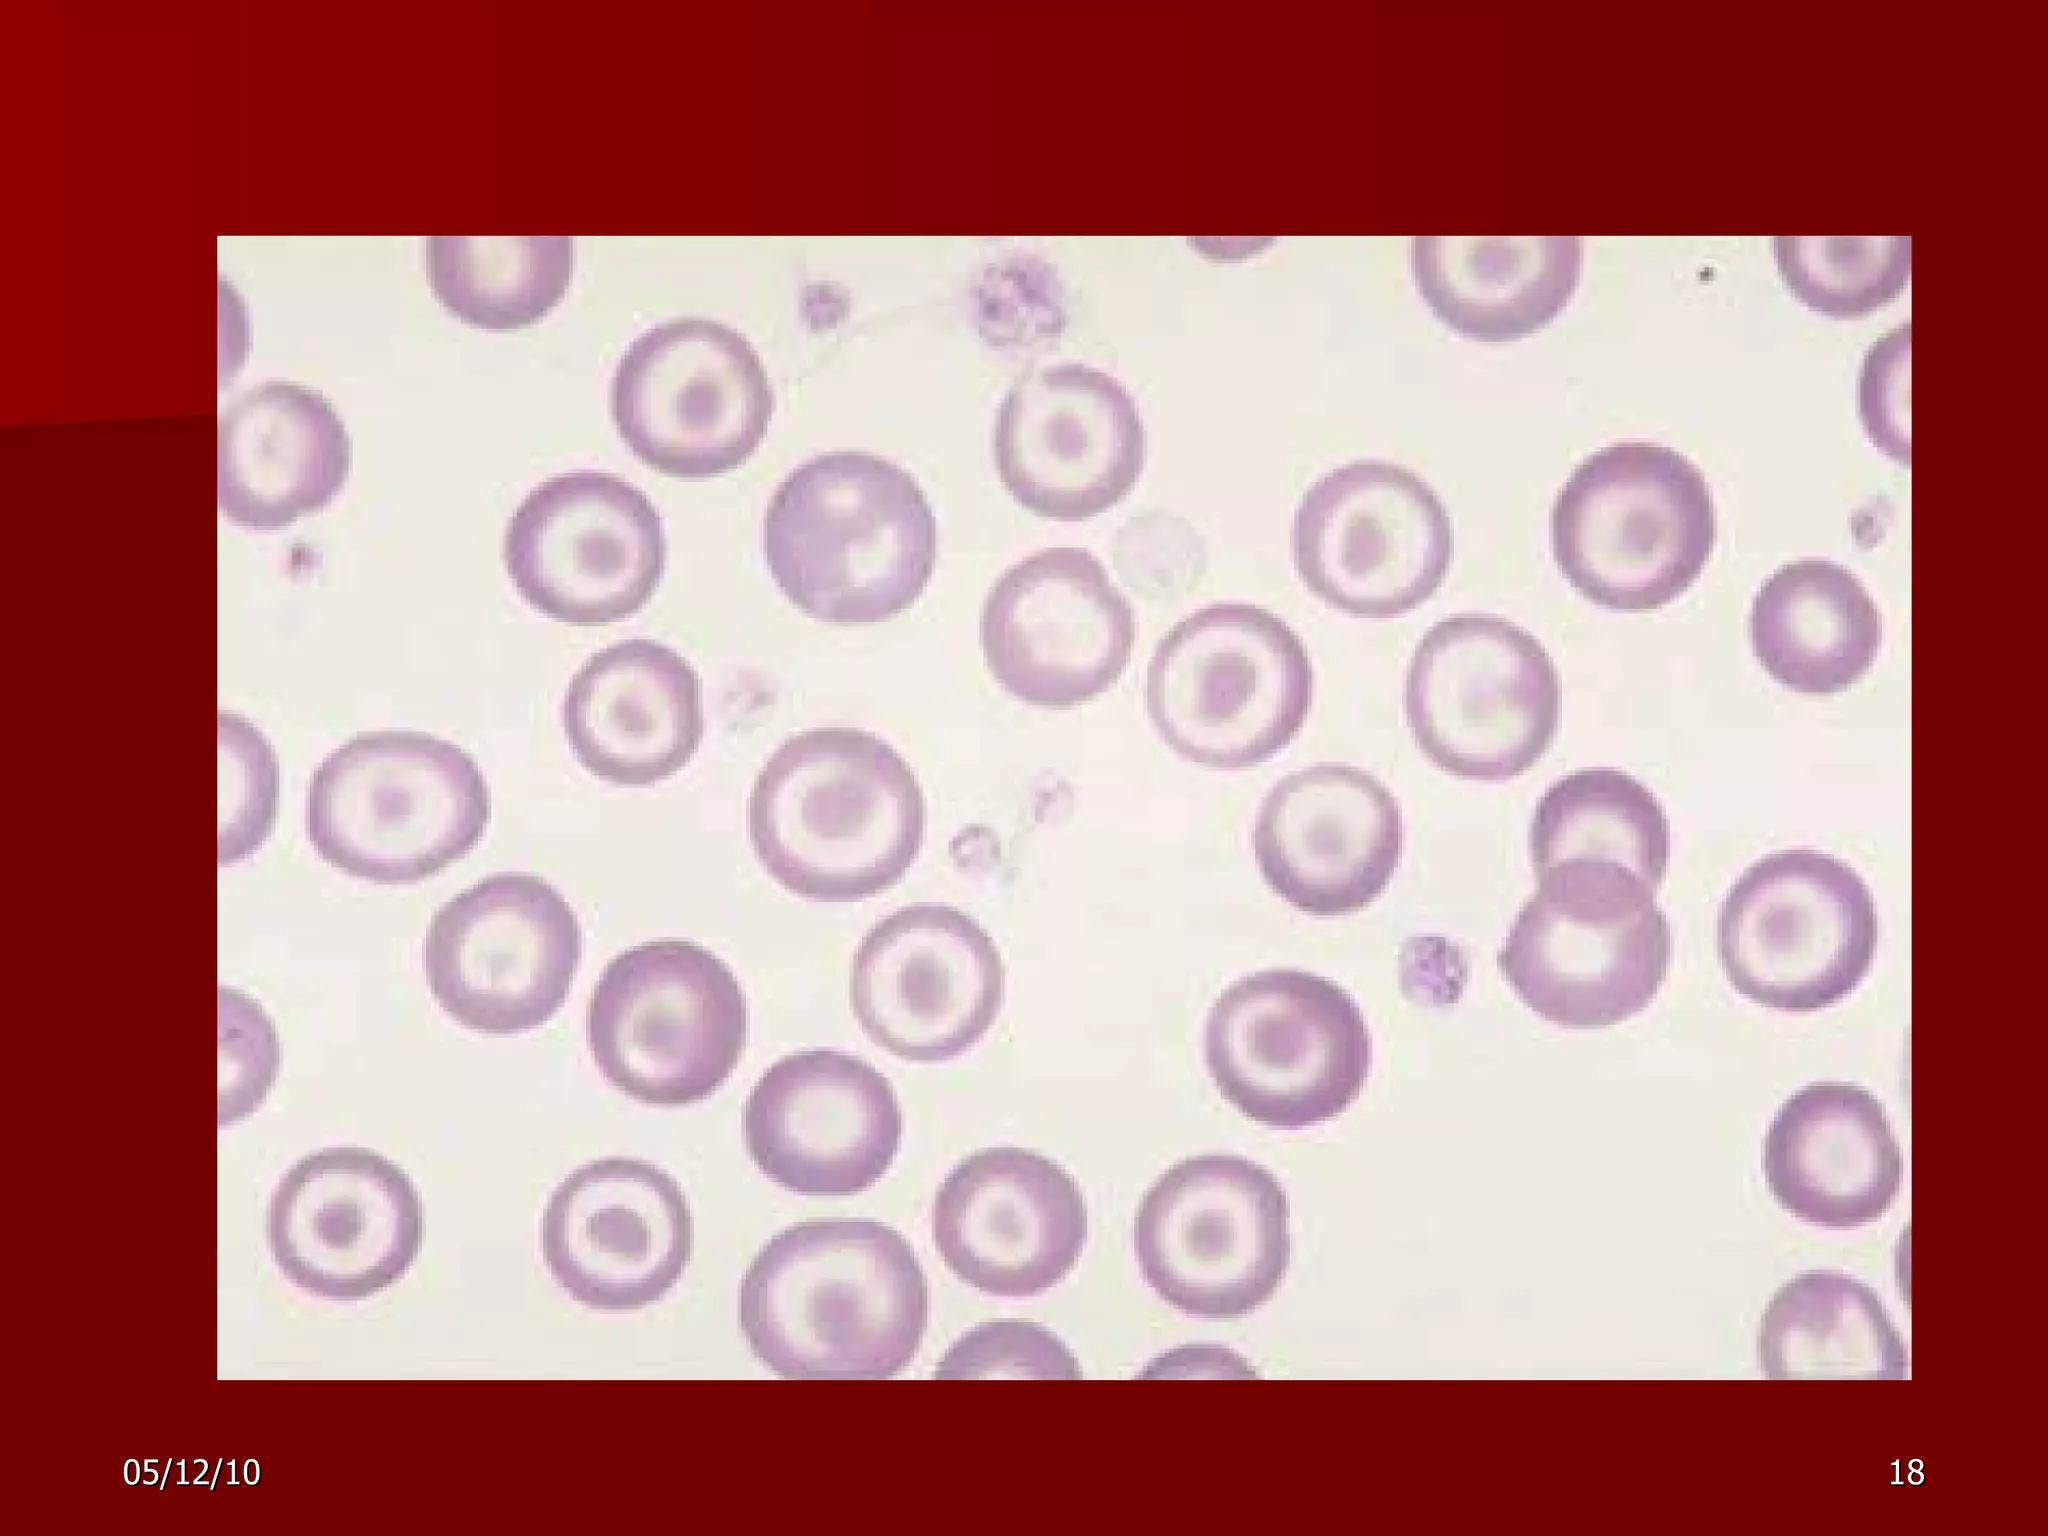
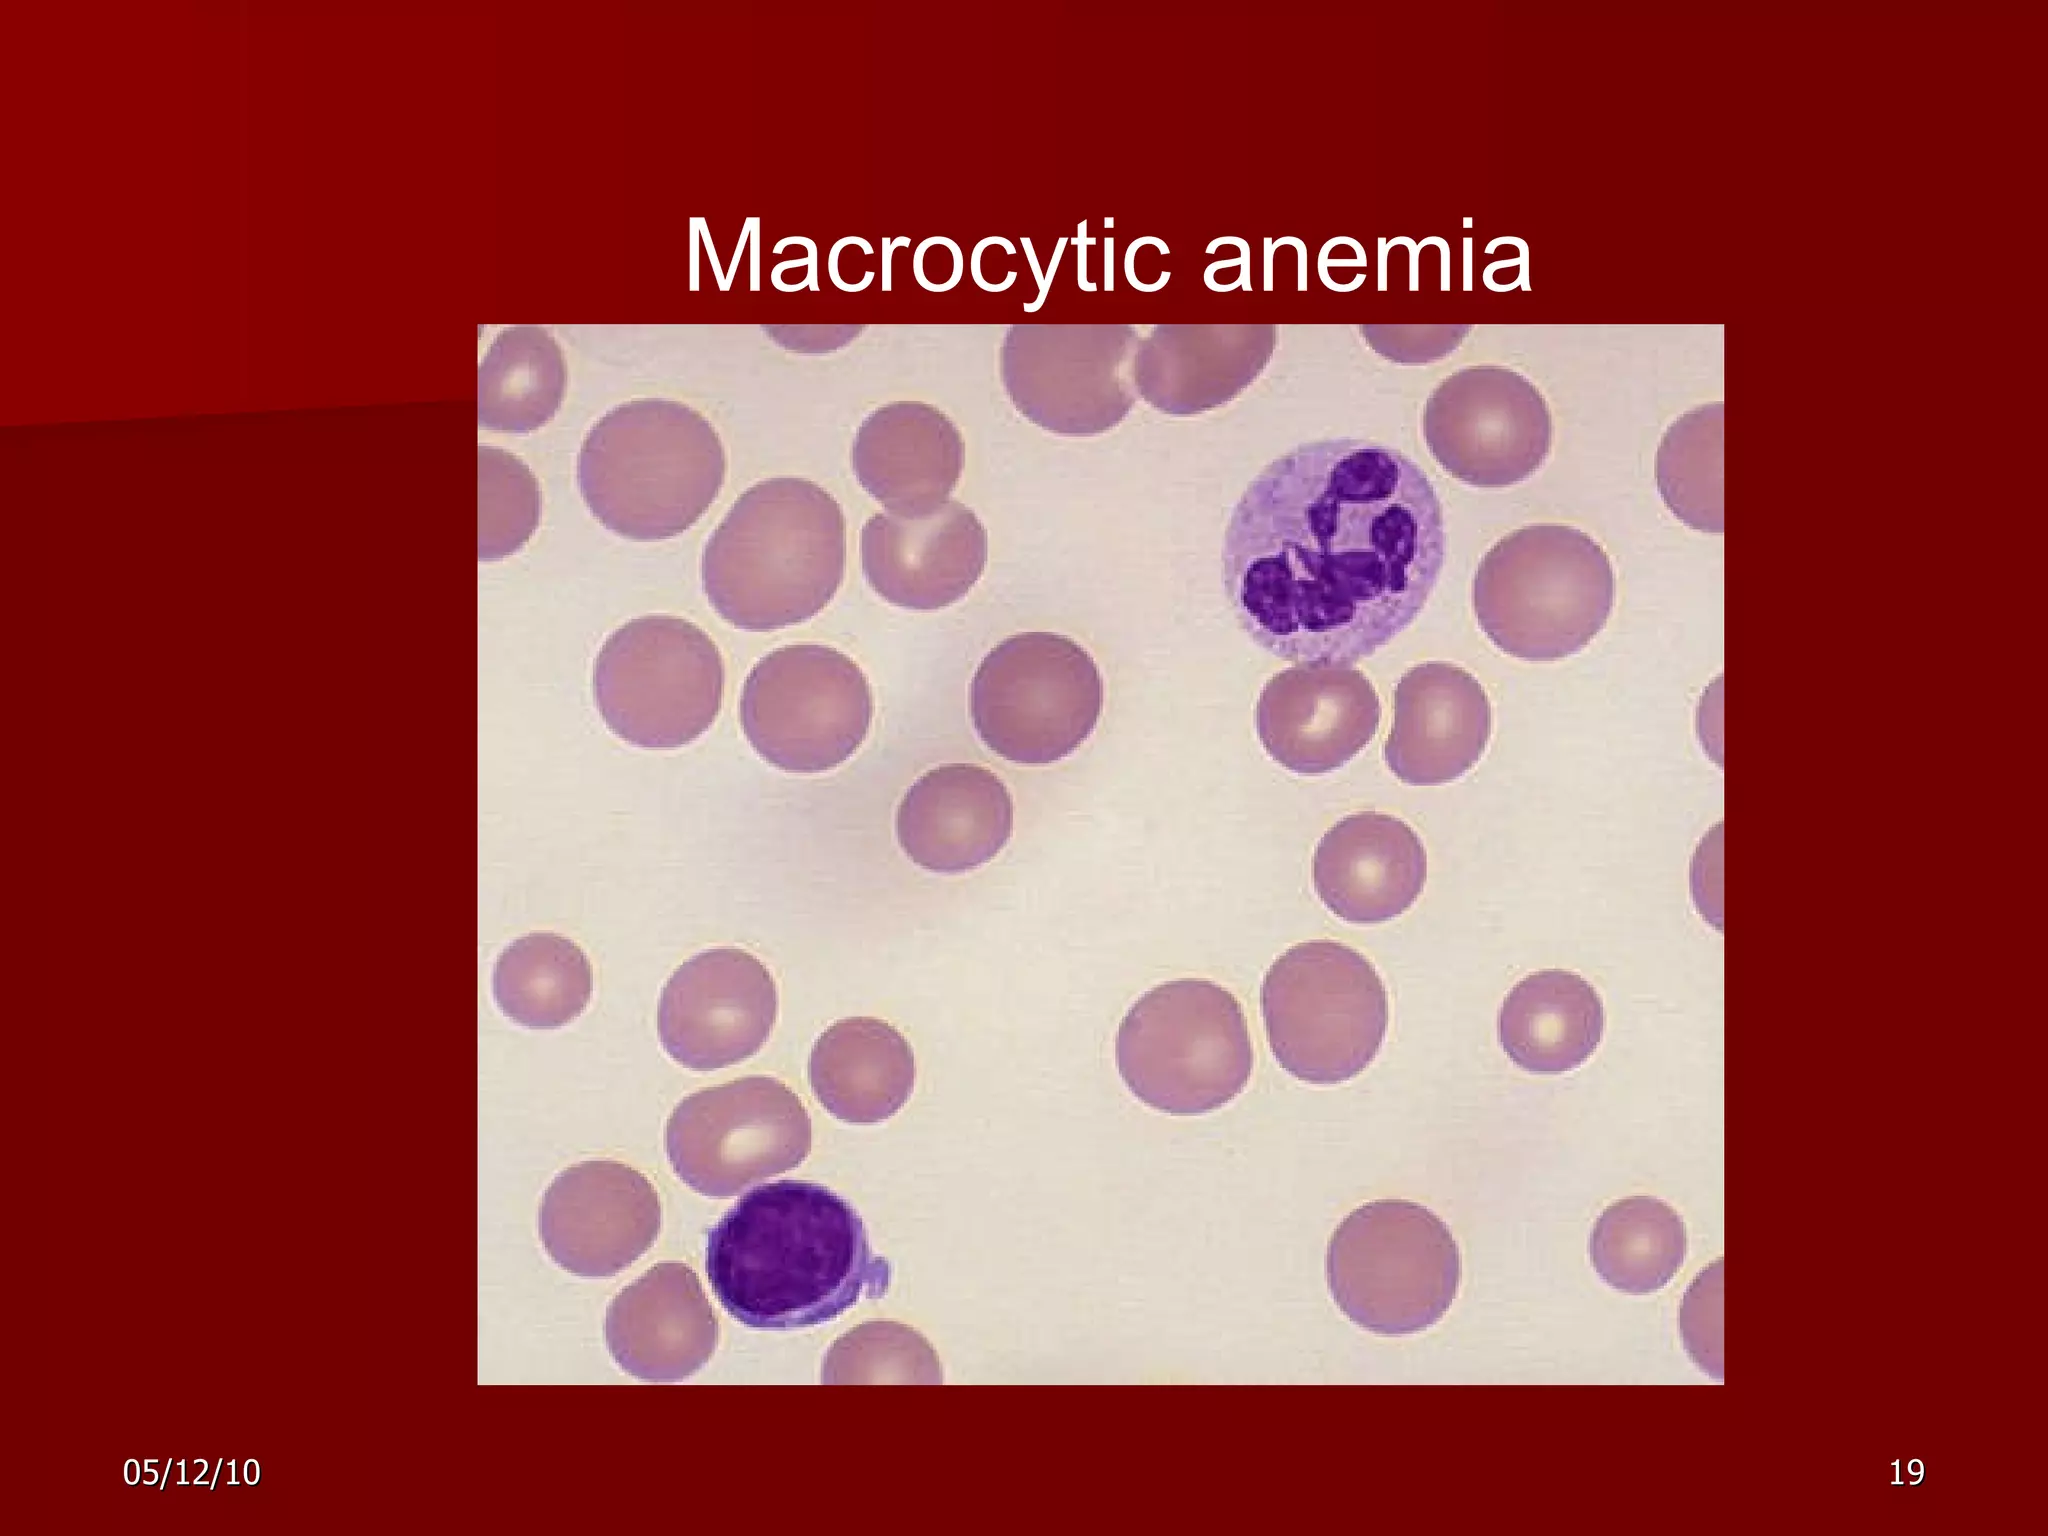
Macrocytic anemia
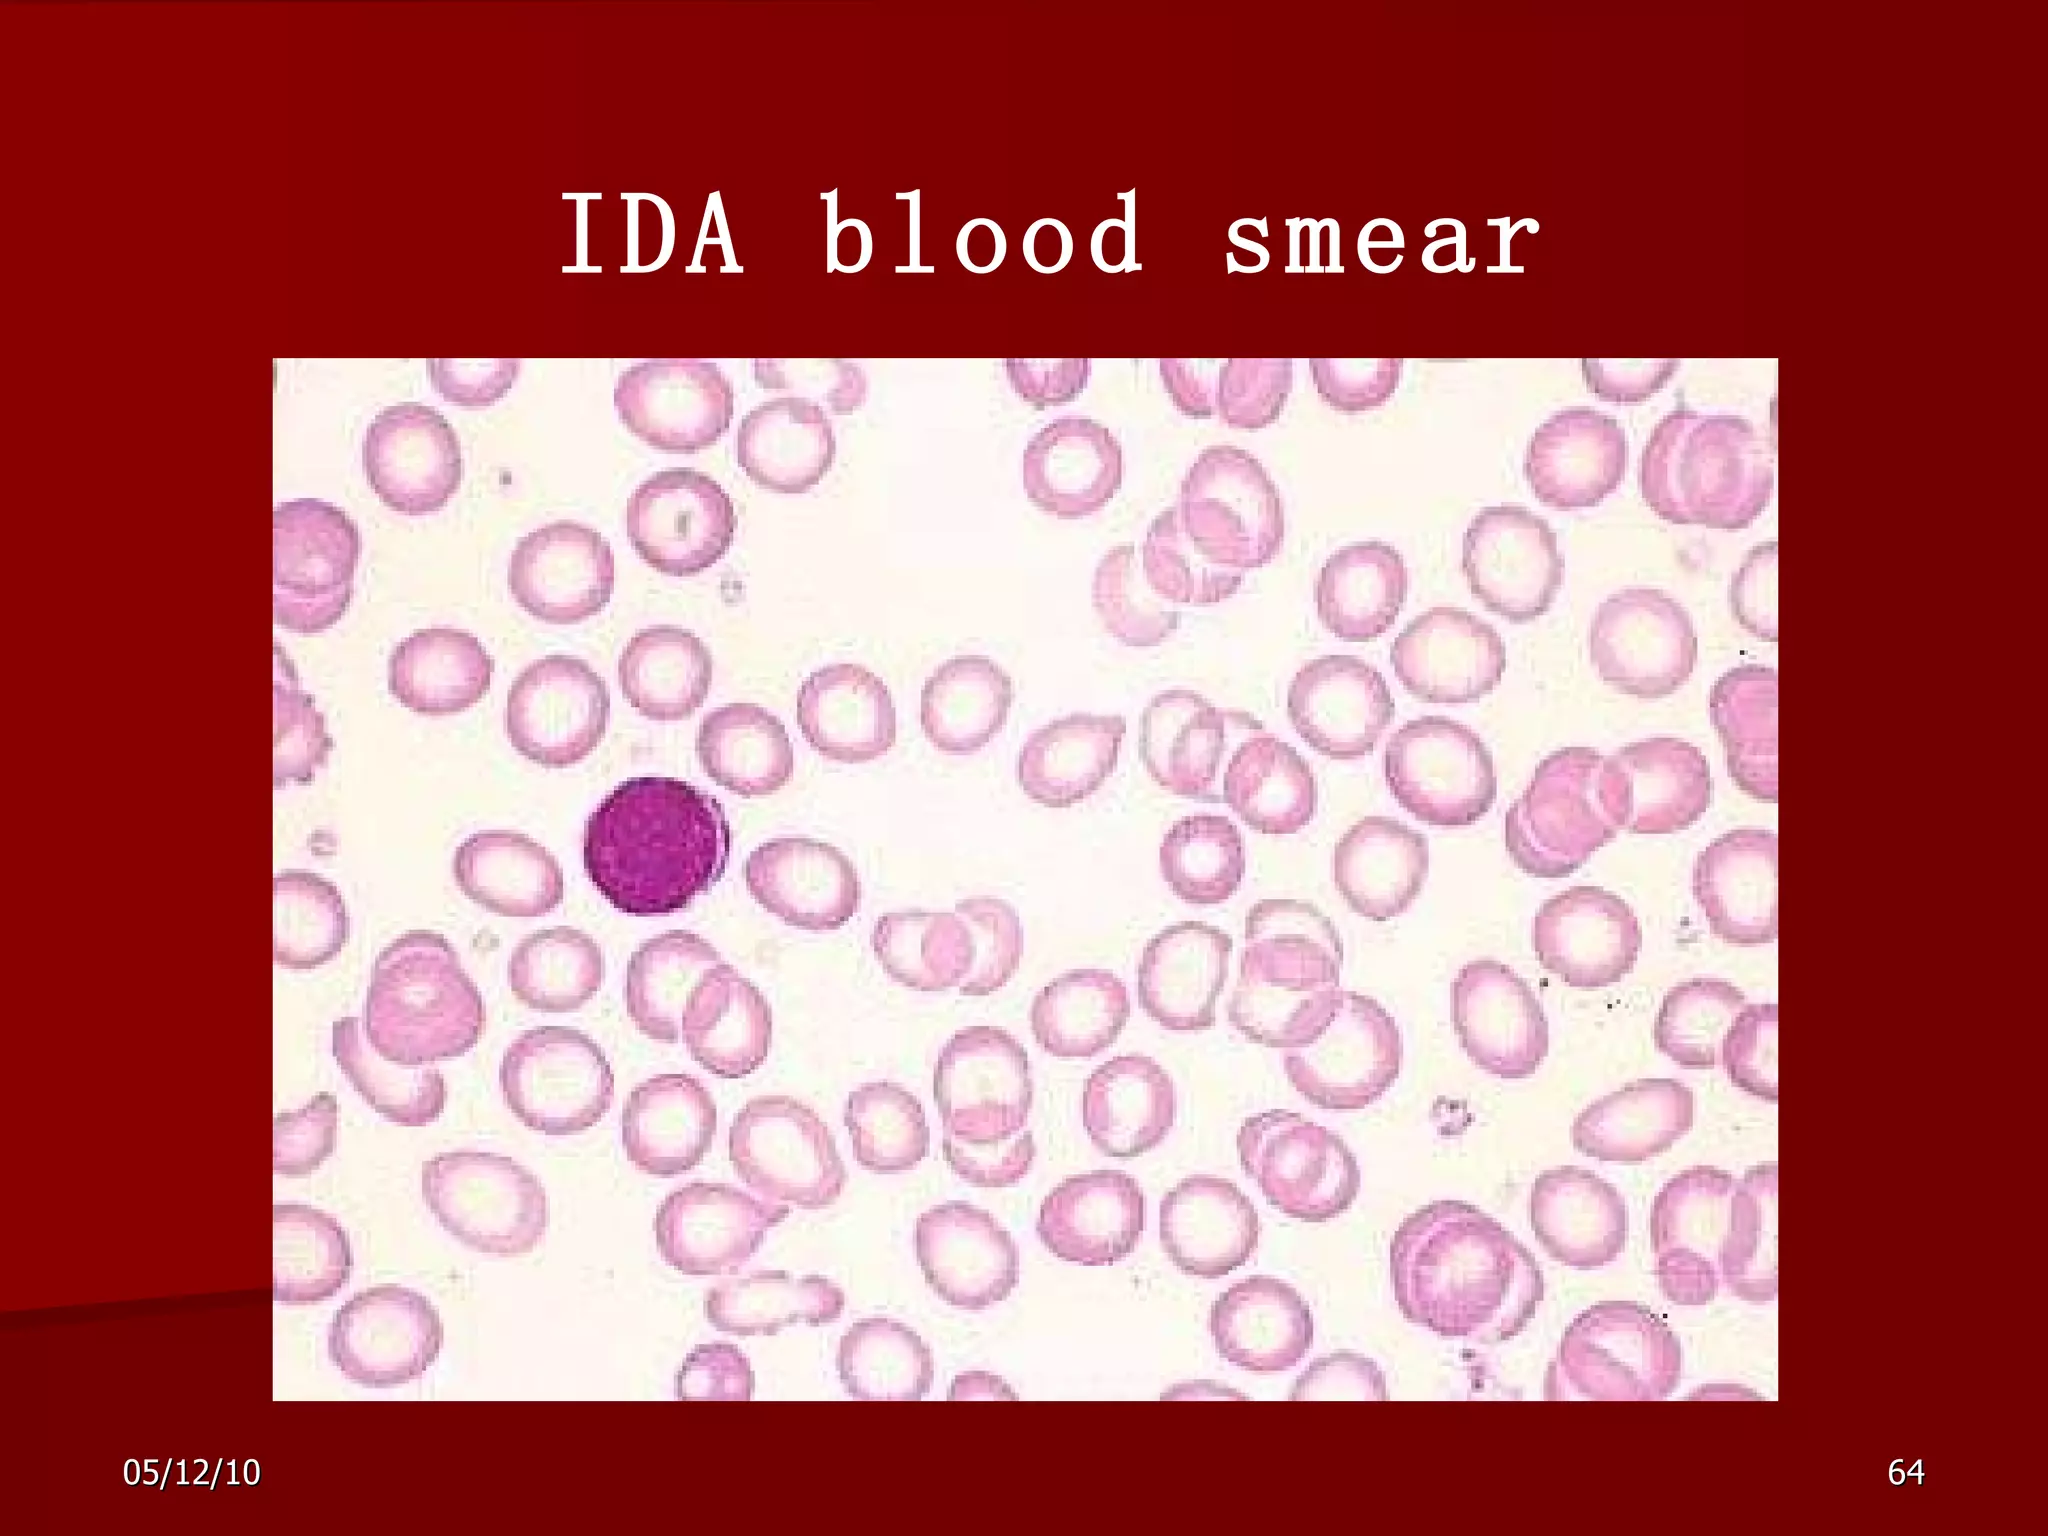
IDA blood smear

Anemia overview document discusses red blood cell parameters, survival and production of RBCs, erythropoiesis process, classification of anemias, common causes, pathophysiology, bone marrow disorders, definitions of aplastic anemia, myelodysplastic syndromes, and acute leukemia. Diagnosis of anemia involves history, physical exam, labs including complete blood count and smears to evaluate RBC size and check for other abnormalities. Treatment focuses on supporting hematopoiesis, blood transfusions, and curing the underlying cause.
![Anemia Overview Ruozhi Xiao The Third Hospital of Sun Yat-sen University [email_address]](https://image.slidesharecdn.com/anemia-100512052022-phpapp02/75/Anemia-1-2048.jpg)